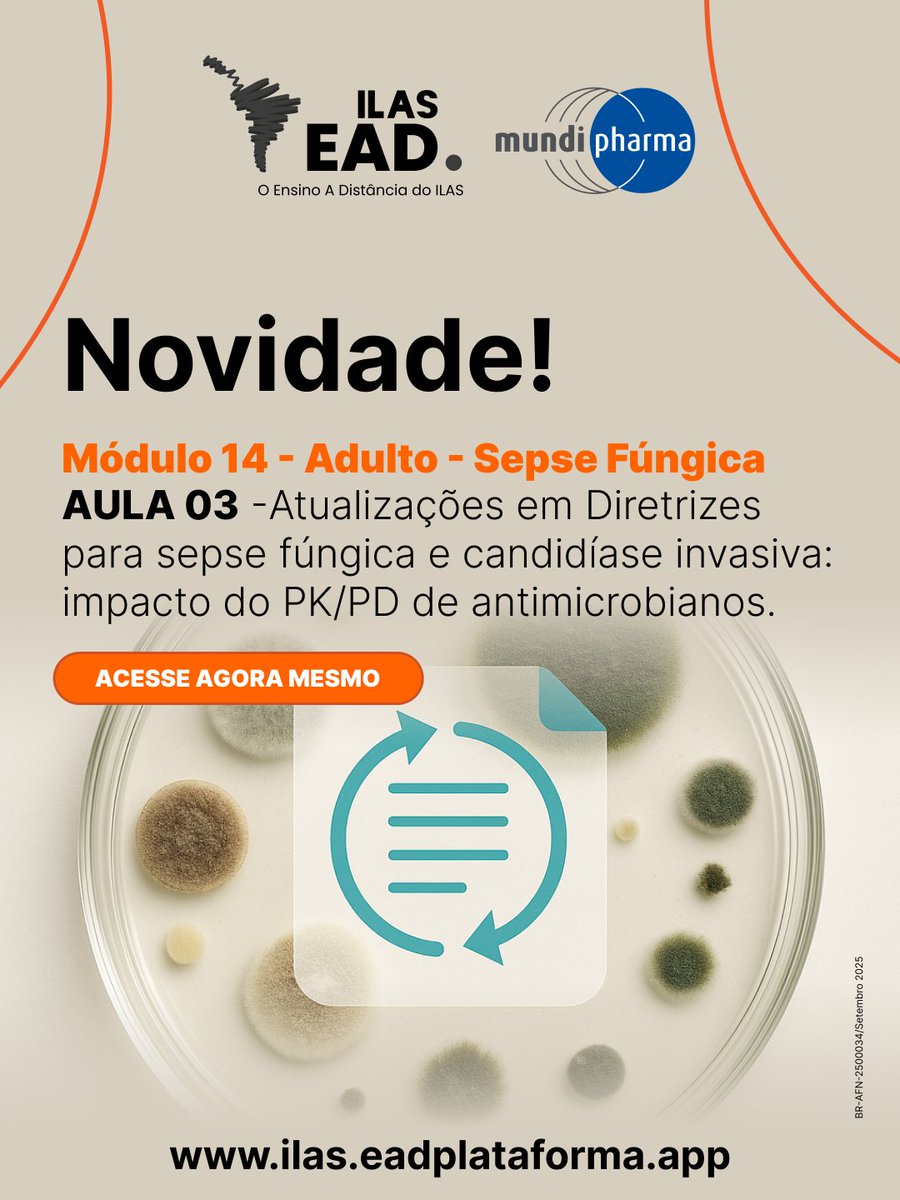
ILAS - Instituto Latino Americano de Sepse tweet media

🚨 Uma jornada completa pelas novas diretrizes da sepse começa aqui.
A atualização 2026 da Surviving Sepsis Campaign será discutida em 3 encontros imperdíveis do Sepse A Live — abordando desde o manejo inicial até os desfechos de longo prazo, incluindo um encontro exclusivo em pediatria.
📚 Confira o cronograma:
📅 24/03 | Manejo hemodinâmico
Reconhecimento e ressuscitação inicial + manejo hemodinâmico
📅 26/03 | Manejo infeccioso, terapias adjuvantes e desfechos
Condutas essenciais e o que há de novo nas evidências
📅 31/03 | Children’s Guideline 2026
Abordagem completa da sepse em pediatria
⏰ Sempre às 20h
📍 Ao vivo no YouTube (youtube.com/ilas-sepse)
Uma oportunidade única para se atualizar com especialistas e levar para a prática o que realmente impacta o cuidado ao paciente com sepse.
👉 Programe-se e participe dos três encontros!

Português